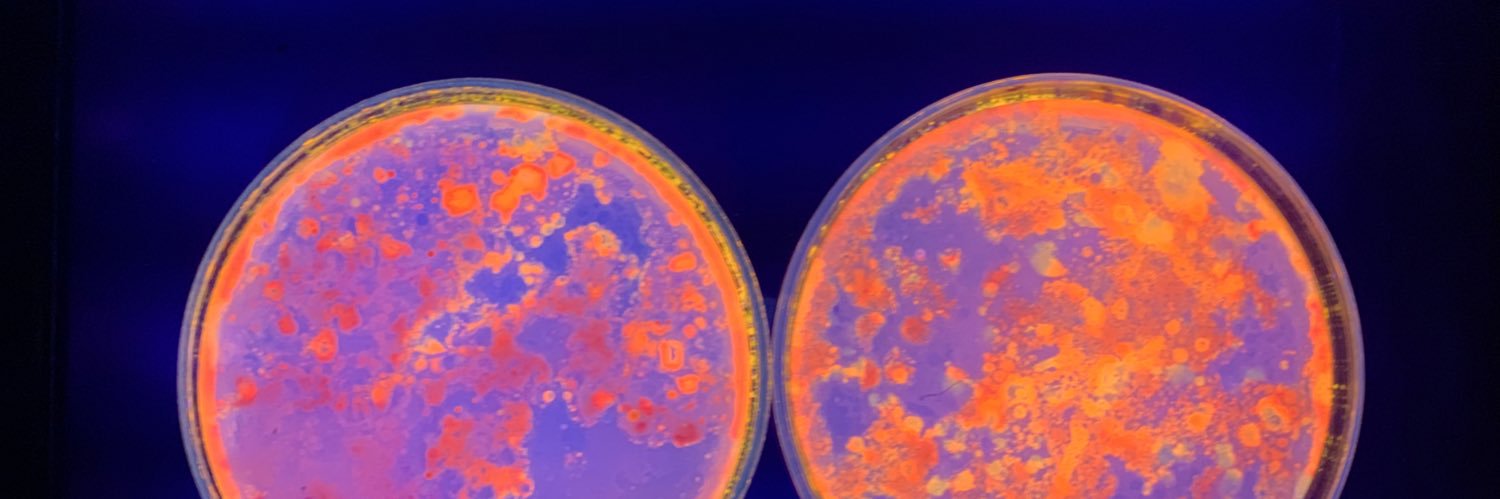
୨ৎmilsss⋅˚₊‧ banner

Sabitlenmiş Tweet

ini ngeri banget, Primata itu reservoir penyakit zoonosis paling berbahaya karena DNA-nya mirip manusia, virus kayak Ebola atau SIV/HIV gampang banget 'lompat' ke kita, belum lagi risiko bakteri patogen dan prion yang merusak saraf, this is literally how pandemics start💀



SobatMiskinTV@MiskinTV_
Ini serius 'monyet' dimasak untuk makanan?
Indonesia